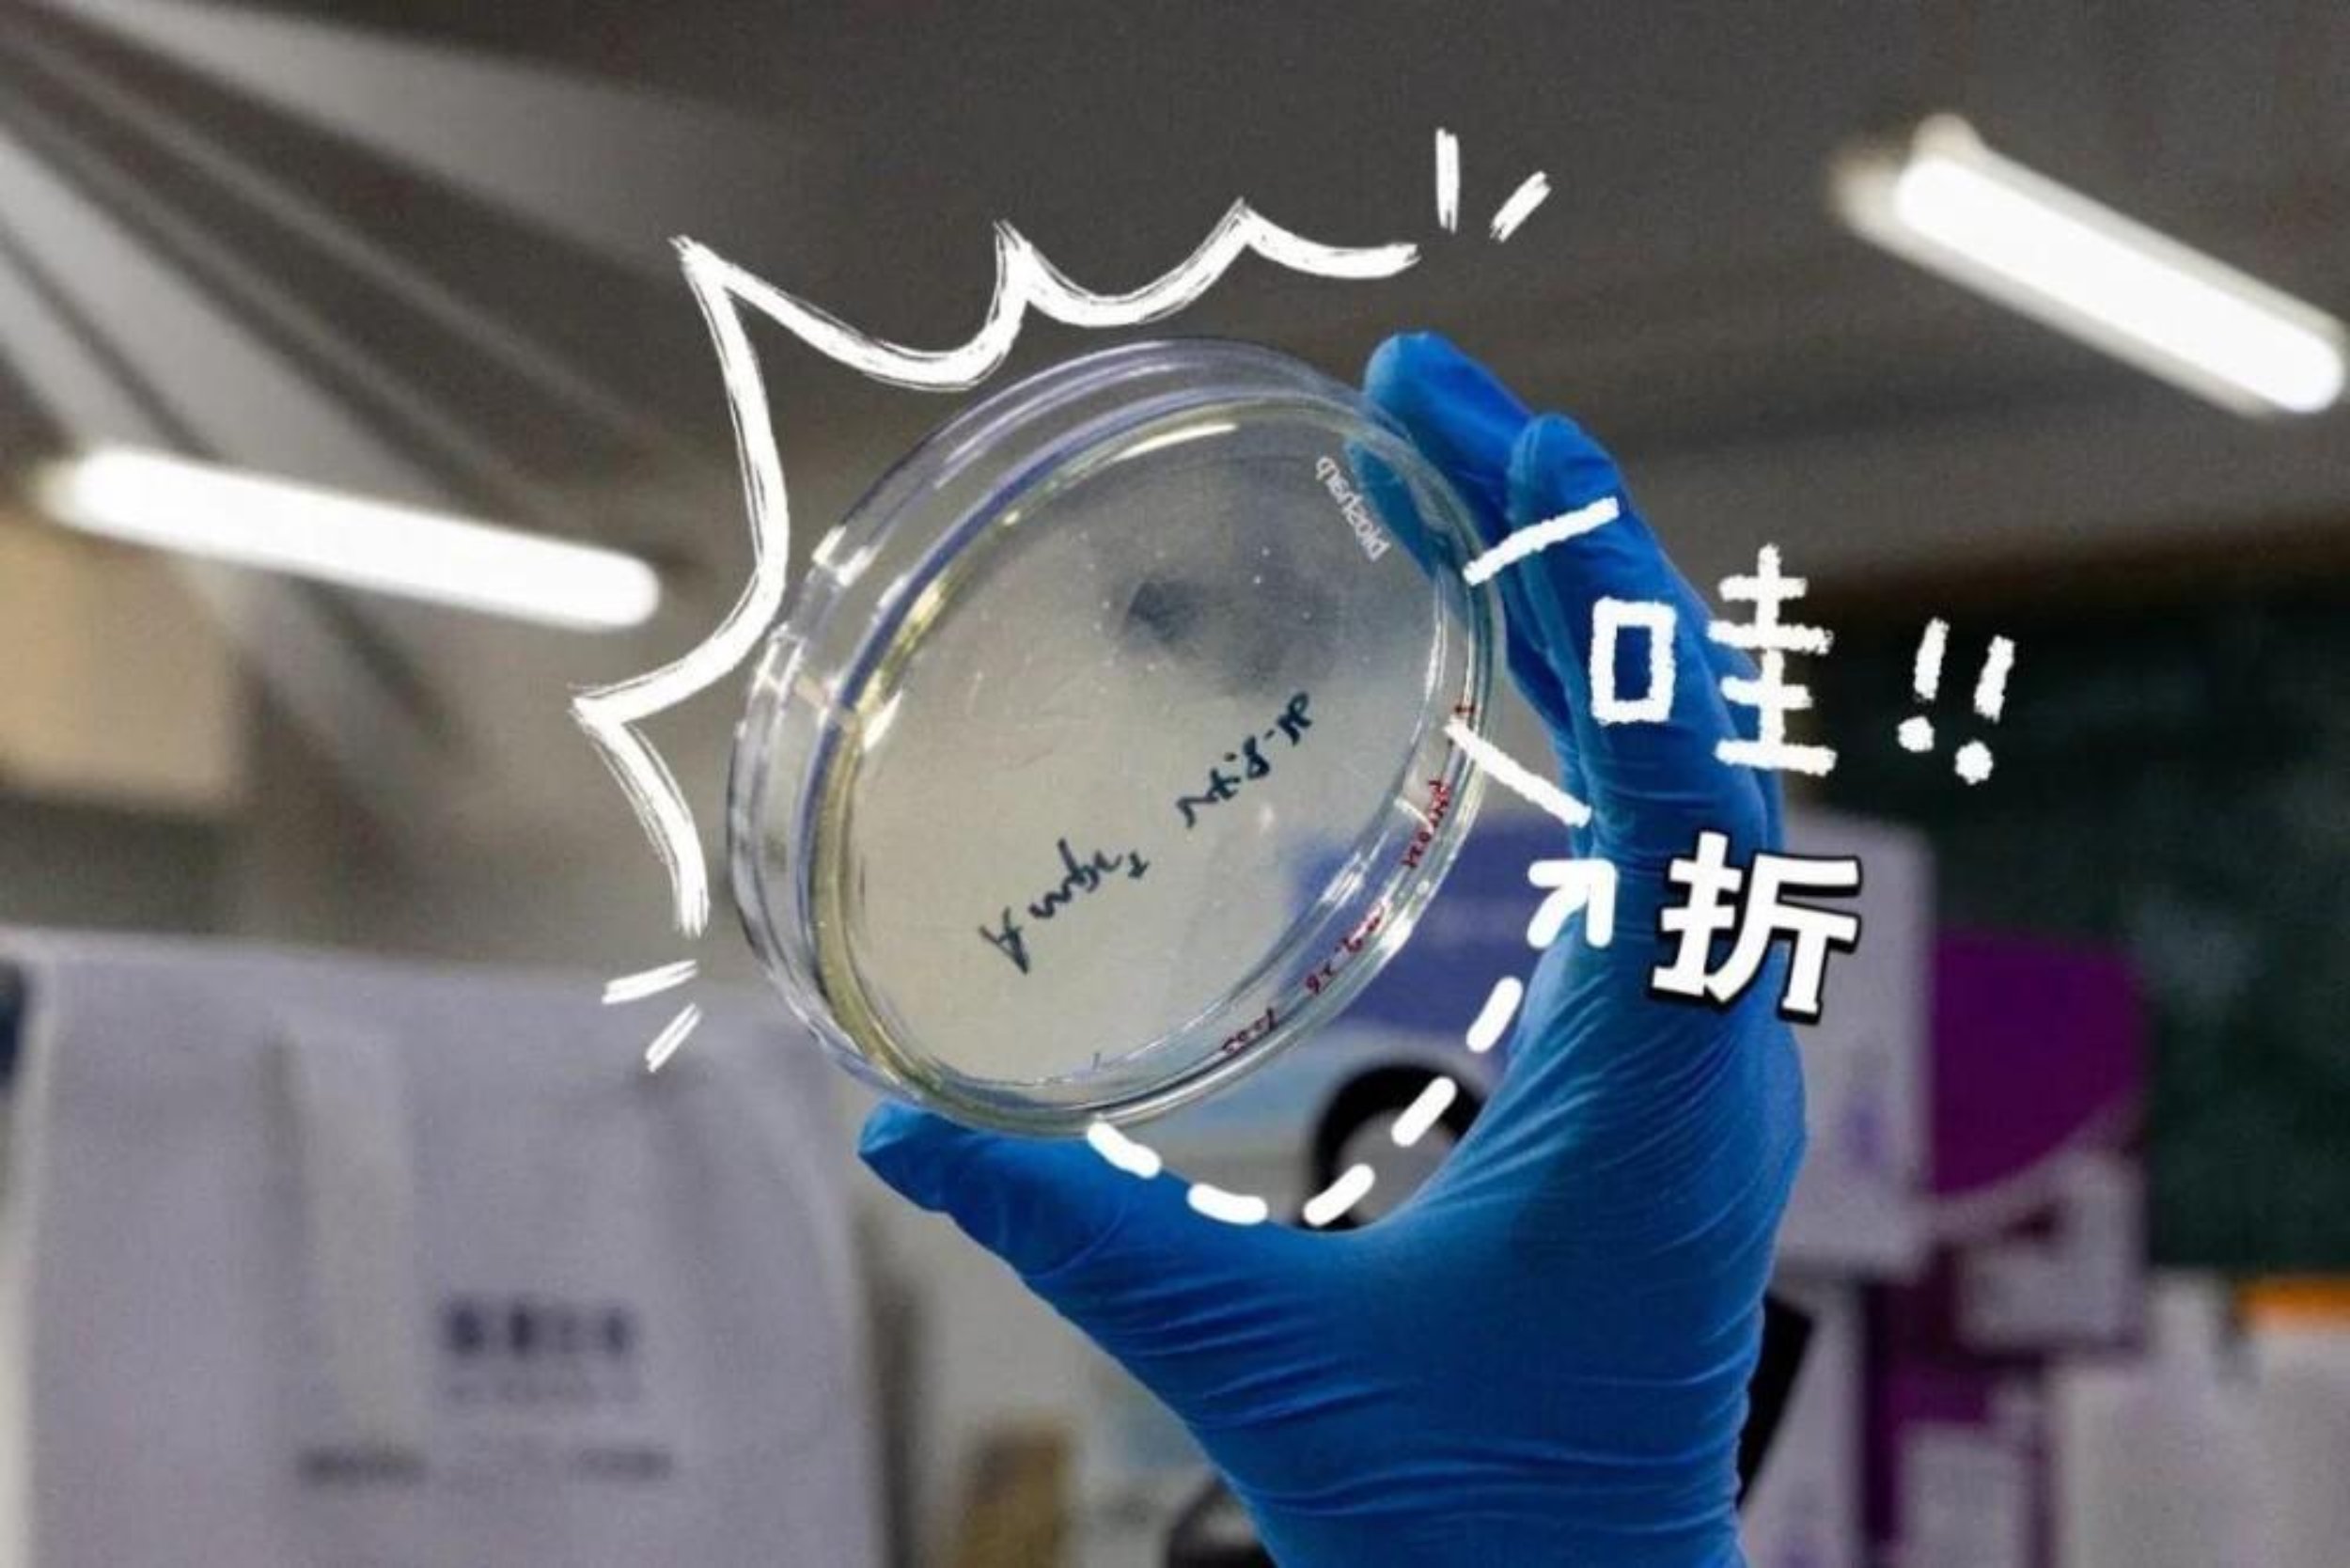

横,如坚韧不拔的脊梁
撑起科大的风骨
竖,似正直不阿的品格
彰显科大的气节
撇,若沉稳如山的底蕴
赋予科大独特的神韵
捺,如蓄势待发的力量
凝聚笔锋的锐意
……
这一笔一划间
都是科大的风景
横
横卧纸间,似天边长虹
汉字之骨,横划显其雄
横之坚毅,如钢如铁
我们如“横”一样
在跨线桥上阔步昂首
在五公里跑道上挥汗如雨
用坚韧连接过去与未来
步伐坚定,使命如山

竖
竖立天地,如松如柏
汉字之魂,竖划显其直
竖之挺拔,正直不阿
我们如“竖”一般
在升旗仪式中站如青松
在战术训练中挺立如旗
以正直铸就忠诚
顶天立地,胸怀家国

撇
撇如流水,舒展自如
汉字之韵,撇划显其柔
撇之沉稳,如山如岳
我们如“撇”一样
在武术表演中行云流水
在实战训练中稳如磐石
以舒展与沉稳铸就战斗力
刚柔并济,不负使命

捺
捺如长风,蓄势待发
汉字之势,捺划显其力
捺之舒展,刚柔并济
我们如“捺”一般
在障碍训练中蓄势跃起
在实战演练中锐意冲锋
以力量书写胜利篇章
一往无前,势不可挡

点
点如星辰,微小却璀璨
汉字之睛,点划显其灵
点之精致,细致入微
我们如“点”一样
在战术地图上标注每一个坐标
在实验数据中捕捉每一处细节
于细微处见真章,于平凡中显不凡
精益求精,追求卓越

折
折如峰峦,转折有力
汉字之变,折划显其韧
折之果敢,破而后立
我们如“折”一般
在野外拉练中突破极限
在科研攻关中迎难而上
以坚韧铸就钢铁意志
迎风破浪,勇往直前
提
提如晨曦,轻盈而坚定
汉字之跃,提划显其扬
提之昂扬,奋发向上
我们如“提”一样
在早操训练中斗志昂扬
在比武竞赛中奋勇争先
以昂扬姿态迎接每一次挑战
志存高远,步履不停

勾
勾如回环,圆满而有力
汉字之收,勾划显其锋
勾之果断,收放自如
我们如“勾”一般
在战术演练中果断收尾
在任务完成后总结经验
以圆满诠释使命担当
再攀高峰,续写辉煌

一笔一划,皆是科大风景
一字一句,尽显科大风骨
在这里
我们用笔墨书写青春
用行动诠释精神
用每一笔,勾勒出科大的未来

